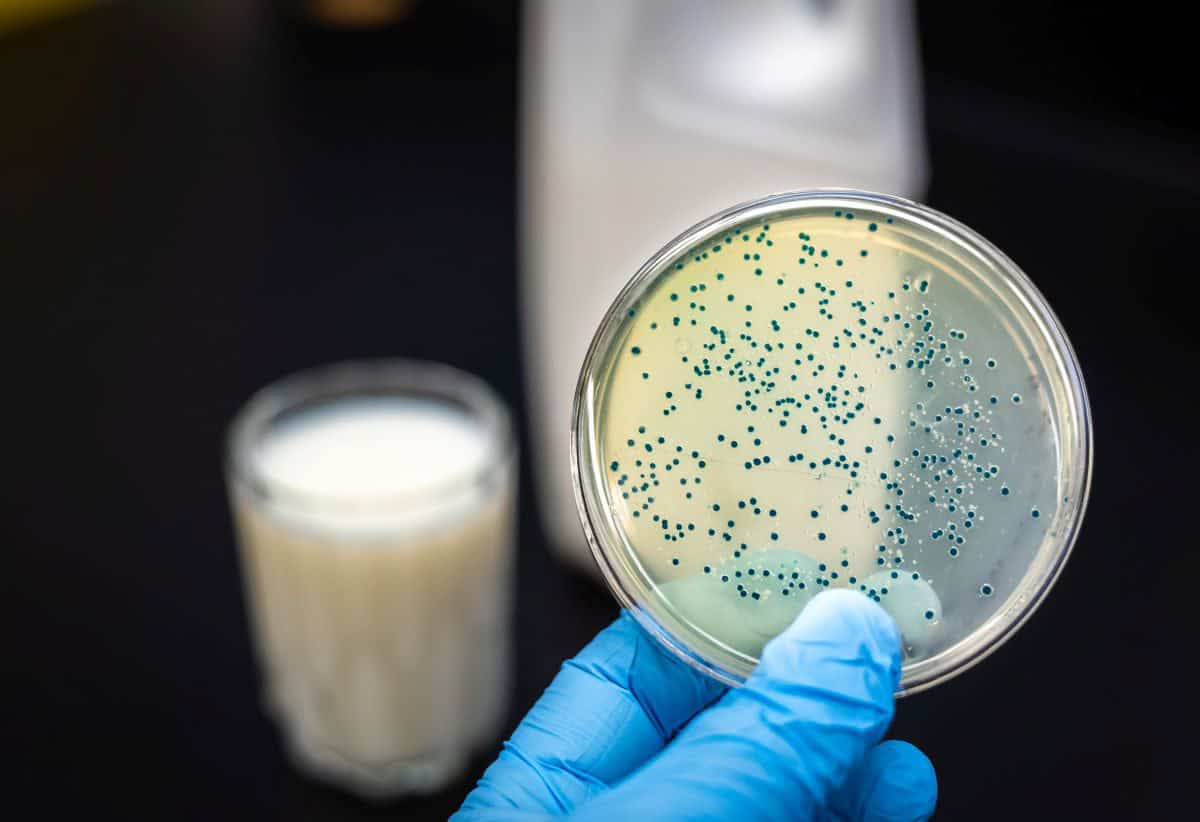
bacteria studies with milk for gut health

You might not think much about the trillions of microorganisms living in your gut, but they play a pivotal role in your health. This diverse community, known as the gut microbiome, aids in digestion, supports your immune system, and even produces essential nutrients.
An imbalance in these microorganisms can lead to a host of health issues, from gut inflammation to metabolic disorders. So, how do scientists study this intricate ecosystem, and what can you do to maintain a healthy gut?
Key Takeaways
- The gut microbiome consists of trillions of bacteria living in the digestive tract.
- It influences digestion, immunity, and mental health.
- A healthy gut microbiome maintains a strong gut barrier and prevents inflammation.
- Diverse gut bacteria help train immune cells and manage chronic diseases.
- Imbalances in the gut microbiome can lead to autoimmune and cardiometabolic diseases.
Turning Microbiome Research Into A Force For Health
You’re probably wondering how microbiome research can actually improve your health.

Studies show that your gut microbiome plays an essential role in autoimmune diseases, gut inflammation, and cardiometabolic disorders.
Gut Microbiome And Autoimmune Disease
Research shows that the gut microbiome plays a significant role in the development and management of autoimmune diseases. Your human gut microbiota, which includes trillions of commensal bacteria, directly influences your immune cells. When the balance of these bacteria is disrupted, it can lead to autoimmune diseases, including inflammatory bowel diseases.
Host-microbe interactions are essential for maintaining immune system balance. A diverse gut microbiome can help train your immune cells to differentiate between harmful pathogens and your body’s own tissues. This microbial diversity is vital for preventing immune system overreactions that can lead to autoimmune conditions.
The gut microbiome impacts intestinal permeability. When your gut lining is compromised, it allows toxins and bacteria to enter your bloodstream, which can trigger inflammation and autoimmune responses. By supporting a healthy gut microbiome, you can help maintain a strong barrier, thereby reducing the risk of autoimmune flare-ups.
Understanding the health benefits of a balanced gut microbiome empowers you to take control of your health. Embracing dietary and lifestyle choices that promote microbial diversity can be a significant step in managing autoimmune diseases and enhancing your overall well-being.
Gut Inflammation/Bowel Disorders
Addressing gut inflammation and bowel disorders is another critical aspect of understanding the gut microbiome’s role in health. When you think about conditions like irritable bowel syndrome (IBS) and clostridium difficile infections, it’s clear that the human gut microbiome plays a central role.
The complex interactions between various types of bacteria in your intestinal microbiota can either trigger or alleviate gut inflammation. A healthy microbiome is key to managing these chronic diseases. Beneficial microbes help maintain the balance, reducing the risk of flare-ups in bowel disorders. For example, in IBS, certain types of bacteria produce short-chain fatty acids that can soothe inflammation.
On the flip side, if harmful bacteria dominate, like in clostridium difficile infections, your gut’s delicate balance is disrupted, leading to severe inflammation and discomfort. Millions of people currently struggle with gut-related chronic diseases.
By fostering beneficial microbes and paying attention to the complex interactions within your gut, you can take significant steps toward reducing gut inflammation and improving your overall well-being.
Gut microbiome composition and cardiometabolic diseases
Understanding the gut microbiome’s composition is essential for grasping its impact on cardiometabolic diseases. The human microbiome’s diversity, both taxonomic and functional, can influence conditions like obesity, diabetes, and heart disease.
When the gut microbiome is balanced, it supports butyrate-producing bacteria, which are important for reducing insulin resistance—a key factor in cardiometabolic diseases. When there’s an imbalance in your gut microbiome, harmful bacteria can thrive, leading to bacterial infections and inflammation. This imbalance can disrupt metabolic pathways and contribute to insulin resistance.
Research reveals that people with greater taxonomic diversity in their gut microbiomes tend to have better cardiometabolic health. Functional diversity, the varied roles these microbial cells play, is just as significant. It helps break down complex carbohydrates, produce vitamins, and maintain gut barrier integrity.
Mechanistic insights from recent studies show that enhancing the gut microbiome with beneficial bacteria can positively affect your metabolic health.
How We Study the Microbiome
To study the microbiome, scientists employ a range of advanced techniques and tools. In microbiome research, understanding the human microbiota involves examining the countless bacterial cells that inhabit our bodies.
By generating and analyzing omics data—such as genomics, proteomics, and metabolomics—researchers can gain a thorough view of these complex communities.
Personalized approaches have become pivotal, allowing scientists to tailor studies based on individual microbiome data. This helps in understanding how unique microbiomes influence health and disease.
Animal models also play a critical role, offering insights into how microbiomes function in living organisms without directly experimenting on humans.
The study of drug-microbiome interactions is expanding, not just focusing on antibiotics but also on non-antibiotic drugs. These studies help in understanding how various medications can alter the bacterial landscape in our bodies.
A multi-omics approach combines different types of omics data to provide a holistic view of the microbiome. This method is proving invaluable in deciphering the complex interactions within the microbiota.
The Human Microbiome Project
You might wonder how we started to understand the gut microbiome so well.
The Human Microbiome Project used metagenomics to map the vast array of microbes in our bodies.
Key institutions like the Alkek Center for Metagenomics and Microbiome Research played pivotal roles in this groundbreaking work.
Metagenomics
The Human Microbiome Project uses metagenomics to explore the vast diversity of microorganisms living in our gut. By sequencing the genetic material of these microbes, scientists can identify the roles they play in our bodies.
The gut microbiome is essential for numerous biological processes, including digestion, immune function, and even mental health. Metagenomics provides a window into how these microorganisms interact with our human cells and influence our overall well-being.
Here’s a simple breakdown of key findings related to the gut microbiome:
| Aspect | Key Insight |
|---|---|
| Human Health | Gut bacteria influence digestion, immunity, and mental health. |
| Human Cells | Microbes interact with human cells to regulate various functions. |
| Biological Processes | They play a role in breaking down food and synthesizing vitamins. |
| Antimicrobial Resistance | Metagenomics helps identify genes responsible for antibiotic resistance. |
| Research Publications | Studies like Nat Rev Microbiol, Cell Metab, Nat Microbiol, and Appl Environ Microbiol showcase important findings. |
The collective efforts of the scientific community aim to reveal how these tiny organisms impact our lives. By deciphering the gut microbiome, we can discover new strategies to enhance human health and combat diseases.
Importance of the Human Microbiome Project
Understanding the significance of the Human Microbiome Project reveals how interconnected our health is with the trillions of microbes living within us. This groundbreaking initiative has shed light on the essential role our gut microbiome plays in influencing various aspects of our well-being.
The Human Microbiome Project has made it clear that an imbalance in these microbial communities can contribute to human diseases, including chronic kidney disease and respiratory diseases.
By studying these microbial populations, researchers have discovered essential bacteria like A. muciniphila, which supports gut health and overall wellness.
The project’s findings, often published in journals like PLOS ONE, emphasize a holistic approach to health, considering the term microbiome as an important factor in maintaining a balanced life.
Here are three key insights from the Human Microbiome Project:
- Disease Connection: Links have been established between the gut microbiome and chronic conditions such as chronic kidney disease and respiratory diseases.
- Brain Health: There’s compelling evidence that our gut microbiome can influence brain health and mental well-being.
- Personalized Medicine: The project advocates for personalized treatments based on an individual’s unique microbiome composition.
Alkek Center for Metagenomics and Microbiome Research
Building on the insights gained from the Human Microbiome Project, the Alkek Center for Metagenomics and Microbiome Research focuses on advancing our understanding of microbial communities and their impact on human health.
At the Alkek Center, researchers use pattern-oriented models to decode complex interactions within microbial communities. These models help you see how gut microbes, such as those breaking down resistant starch, affect your overall health.
The center also examines the role of the cell wall in microbial interactions, which can provide insights into fungal diseases and potential new treatments.
If you’ve undergone bariatric surgery, the center’s research can help you understand how your altered gut microbiome impacts your recovery and long-term health. For those dealing with coeliac disease or atopic dermatitis, the studies here may lead to better management and treatment options.
Bacteria: Types, characteristics, where they live, hazards, and more
Many different types of bacteria inhabit your gut, each with unique characteristics and essential roles. These bacteria help digest food, produce vitamins, and protect you from harmful pathogens. Understanding them better can make you feel more connected to your own body and its incredible complexity.
- Types: Your gut is home to a variety of bacteria, including Bacteroidetes, Firmicutes, and Actinobacteria. Each type has a specific function, from breaking down complex carbohydrates to producing essential nutrients.
- Characteristics: These bacteria vary in shape, size, and metabolic activity. Some are anaerobes, thriving without oxygen, while others need it to survive. Their diverse traits help maintain a balanced gut environment.
- Where They Live: Bacteria are strategically located throughout your digestive tract. Most reside in the colon, where they aid in the final stages of digestion. A smaller number inhabit the small intestine and stomach, each adapting to the unique conditions of their specific location.
However, not all bacteria are beneficial. Harmful bacteria can cause infections and disrupt your gut balance, leading to issues like inflammatory bowel disease.
Understanding Gut Microbiome Research And How It Affects Your Health
Understanding gut microbiome research is essential to grasping how it impacts your overall health. The complex ecosystem of trillions of microorganisms in your digestive system plays a crucial role in various bodily functions, from digestion to immune response and even mental health.
As research continues to unveil the intricate relationships between gut health and overall well-being, it becomes clear that maintaining a balanced microbiome is vital.
Incorporating a diverse and fiber-rich diet, reducing stress, and avoiding unnecessary antibiotics are just a few steps you can take to support a healthy gut microbiome. Staying informed about the latest research can help you make more informed decisions about your health.
By understanding and nurturing your gut microbiome, you are taking proactive steps towards a healthier, more balanced life. Whether it’s through dietary changes, probiotics, or lifestyle adjustments, the power to improve your gut health is in your hands. Stay curious, stay informed, and embrace the journey to better health through a deeper understanding of your gut microbiome.














